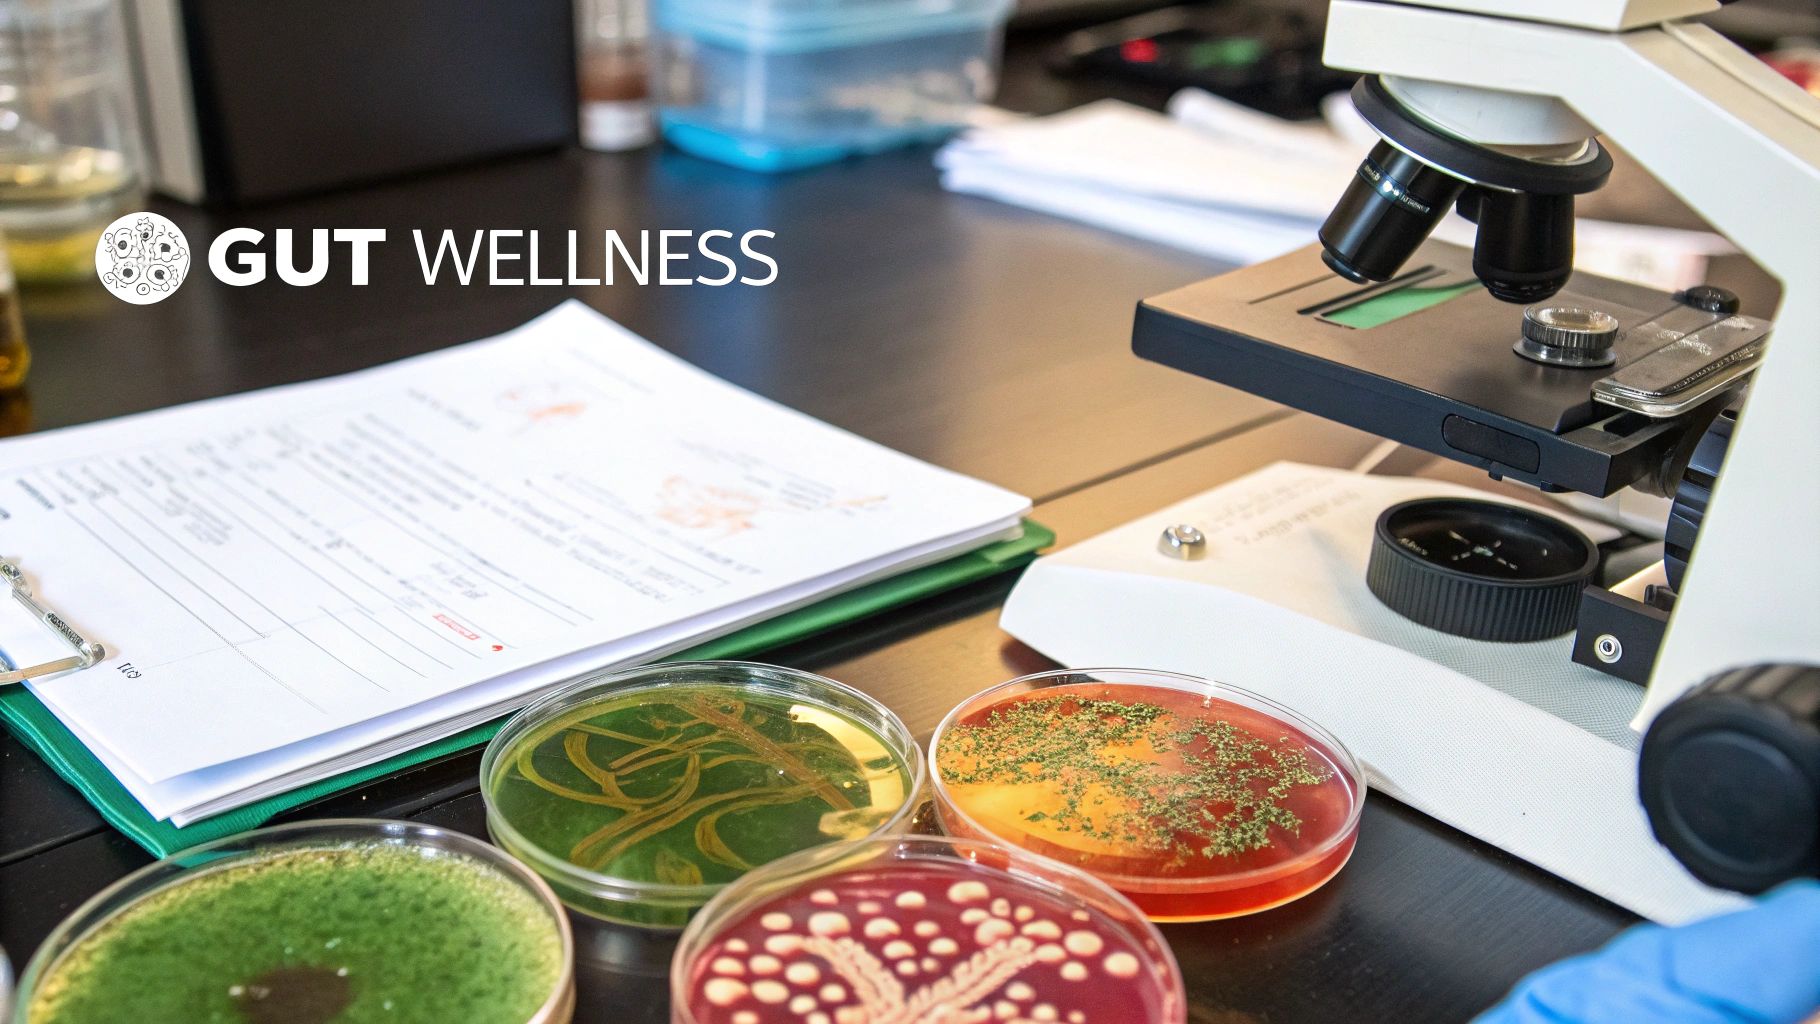
Image

CoreBiome Tributyrin Supplements: Complete Guide to Gut Health (2025)
If you’ve been digging into gut health, you've probably come across the term CoreBiome® Tributyrin. This isn't just another supplement; it’s a next-generation postbiotic specifically engineered for targeted delivery deep into your colon.
Unlike probiotics that introduce new bacteria or prebiotics that feed them, a CoreBiome tributyrin supplement takes a more direct route. It delivers beneficial compounds exactly where your body needs them most, making it a serious upgrade for anyone focused on their digestive wellness. One excellent example is the Tributyrin Postbiotics Capsules (with corebiome), which leverage this advanced technology for maximum gut support.
Your Guide to Advanced Gut Health with CoreBiome
The world of gut health supplements can feel a bit crowded and confusing. You’ve got probiotics, prebiotics, and now, postbiotics. While they all aim for a healthy gut, they work in very different ways.
To clear things up, let's quickly compare them.
Postbiotics vs Probiotics vs Prebiotics at a Glance
| Supplement Type | What It Is | Primary Function | Example |
|---|---|---|---|
| Probiotics | Live beneficial bacteria | Introduces "good" microbes to the gut | Yogurt, Kefir, Sauerkraut |
| Prebiotics | Specific types of fiber | Feeds the good bacteria already in the gut | Onions, Garlic, Chicory Root |
| Postbiotics | Bioactive compounds from bacteria | Directly delivers beneficial byproducts | Tributyrin, other SCFAs |
As you can see, postbiotics skip a few steps. Instead of adding bacteria (probiotics) or feeding them (prebiotics) and hoping for the best, postbiotics deliver the finished product—the beneficial compounds themselves—ready for your body to use. This is precisely where tributyrin comes in.
What Makes Tributyrin So Special?
Tributyrin is a superior form of butyrate, a critical short-chain fatty acid (SCFA). Think of butyrate as the preferred fuel source for the cells that line your colon, known as colonocytes. For these cells to function properly and maintain the integrity of your gut wall, they need a steady supply of butyrate.
Why does that matter? A strong gut barrier is your body's first line of defense. It acts like a meticulous gatekeeper, deciding what gets into your bloodstream and what stays out. When this barrier is compromised—a condition often called "leaky gut"—undigested food particles, toxins, and unwanted microbes can slip through, causing issues throughout the body.
By directly nourishing your colon cells, tributyrin helps to fortify this vital barrier.
The big challenge with most butyrate supplements has always been delivery. Standard forms often get absorbed way too early in the digestive process, meaning they never reach the large intestine where they're needed most. This is exactly the problem that the patented CoreBiome® technology was created to solve.
The unique structure of CoreBiome® shields the butyrate, allowing it to survive the journey through the stomach and small intestine. It’s only when it arrives in the colon that the butyrate is released, providing targeted support right where it counts.
For anyone looking for these direct benefits, the Tributyrin Postbiotics Capsules with CoreBiome from Peak Performance is a perfect example of this advanced science in action. This precision delivery is what truly sets a CoreBiome tributyrin supplement apart from the rest.
Understanding Butyrate: The High-Octane Fuel for Your Gut

Before we can really grasp why tributyrin is such a game-changer, we have to talk about its active payload: butyrate. Think of butyrate as the premium, high-octane fuel that powers the cells lining your colon (your colonocytes).
In a perfect world, our bodies would produce all the butyrate we need. It's a natural byproduct that's created when our friendly gut bacteria get to work fermenting the dietary fiber we eat. It's a beautiful system, but it's often not that simple. Many modern diets are notoriously low in diverse fibers, and everyone's gut microbiome is unique. This means a lot of us are running on a low tank, simply not producing enough butyrate on our own.
That’s where a smart supplement like a corebiome tributyrin supplement steps in to bridge the gap.
The Power Plant for Your Colon
The cells lining your colon have an incredibly demanding job. They’re constantly working, absorbing water and vital nutrients while also standing guard to form a protective barrier against anything harmful. This kind of work takes a ton of energy.
And where does that energy come from? Butyrate. It provides a whopping 70% of the total energy these hardworking colonocytes need to function at their peak.
When butyrate levels are low, these cells start to struggle. It’s like trying to run a high-performance engine on low-grade fuel—things just don't work as well. The result is a weaker, less efficient gut lining.
Butyrate isn't just simple fuel. It's also a powerful signaling molecule that talks to your cells, directing traffic and regulating processes that are absolutely critical for both gut health and your overall well-being. It's the master conductor for your colon's cellular orchestra.
This makes butyrate an indispensable player in keeping your entire digestive system structurally sound and running smoothly.
Fortifying Your Gut Wall
One of butyrate's most important jobs is to strengthen the gut barrier itself. It helps to reinforce the "tight junctions" between the cells of your intestinal wall. Imagine the bricks of a wall; the tight junctions are the mortar holding them together.
When that mortar is strong, the barrier is secure and selective. It lets the good stuff (nutrients) pass through while keeping the bad stuff (toxins, undigested food, and pathogens) out. This is your first line of defense against what’s commonly known as "leaky gut," or increased intestinal permeability.
A strong gut wall has a massive ripple effect on your immune system. With so much of your immune system housed in the gut, a sealed barrier means less stress and fewer false alarms. Your immune cells can then focus on real threats instead of overreacting to things that have leaked into your bloodstream.
Our Tributyrin Postbiotics Capsules (with corebiome) are specifically formulated to deliver butyrate directly to the colon, where it can get to work on this crucial task.
Calming Inflammation and Balancing Your Inner Ecosystem
Chronic, low-grade inflammation is a silent troublemaker in the gut, linked to everything from digestive issues to systemic health problems. Butyrate is a key player in keeping this inflammation in check. It has a calming effect on the immune cells in the gut lining, fostering a more balanced and less reactive state.
But it doesn't stop there. Butyrate actively helps shape the gut microbiome for the better. It creates a friendly environment that encourages the growth of other beneficial, butyrate-producing bacteria. It’s a positive feedback loop that helps build a more diverse and resilient gut ecosystem.
To put it simply, here are butyrate's critical roles:
- Energy Source: The primary fuel for your colon cells.
- Gut Barrier Integrity: Strengthens the gut wall to prevent "leaky gut."
- Inflammation Control: Helps calm and regulate inflammatory responses in the gut.
- Microbiome Support: Creates an environment where good bacteria flourish.
This clear and pressing need for butyrate sets the stage for a targeted solution. The biggest challenge has always been how to get this amazing compound to the colon intact—which is exactly what we'll dive into next.
The Science of Targeted Delivery with CoreBiome Tributyrin
The real power of a corebiome tributyrin supplement isn't just what it is, but how it gets where it needs to go. For years, the biggest challenge with butyrate supplements has been getting them to the colon intact. Most standard forms, like butyrate salts, break down and get absorbed way too early in the stomach or small intestine.
Essentially, they never reach their final destination. It’s like sending a critical package through a storm with no protective wrapping—it's destroyed long before it arrives. This is where a much smarter delivery system comes into play, ensuring the payload arrives safely and is released at just the right moment.
The Smart Delivery Drone Analogy
Think of CoreBiome® Tributyrin as a sophisticated, pre-programmed delivery drone. Its mission is to carry its precious cargo—butyrate—all the way through the harsh, acidic environment of your upper digestive tract and drop it off precisely in the large intestine.
This "drone" isn't a piece of tech, but a unique molecule. It's made of three butyrate molecules chemically fused to a glycerol backbone. This clever structure acts as a natural shield, making the butyrate unavailable for absorption in the stomach and small intestine. It effectively travels undercover, ignored by the early stages of digestion.
This design makes all the difference. It prevents the butyrate from being wasted by premature absorption—the key failure of so many other butyrate supplements—and allows it to continue its journey to the colon where it can finally get to work.
Precision Release in the Colon
Once this tributyrin molecule finally reaches the large intestine, it meets specific enzymes produced by your gut called lipases. These enzymes act as the "key," unlocking the glycerol backbone and setting the three butyrate molecules free.
This release mechanism is brilliant for two main reasons:
- It’s targeted: The butyrate is released exactly where your colon cells need it most for energy and to support the gut barrier.
- It’s gradual: The release isn’t a sudden flood. Instead, it provides a steady, sustained supply of fuel for your colonocytes.
This targeted, time-released action is what gives CoreBiome® its superior bioavailability. Instead of a big, ineffective dose that mostly gets lost along the way, you get a smaller, far more efficient dose that does its job with military precision.
The genius of CoreBiome® is that it uses your body's own natural digestive processes to its advantage. By bonding butyrate to a glycerol molecule, it creates a form that can only be 'unlocked' by the lipase enzymes present in the colon, guaranteeing targeted delivery.
This ensures every milligram makes a maximum impact right where it matters most.
This graphic really helps visualize the journey, breaking down the targeted delivery process of a corebiome tributyrin supplement.

As the infographic shows, the supplement moves from ingestion all the way to a precise release in the intestine, where it can directly support the health of your gut lining.
Why This Matters for Your Gut Health
At the end of the day, this advanced delivery system means more reliable and effective results for you. When you take a supplement, you expect it to work. With CoreBiome® Tributyrin, you can be confident that the active ingredient is actually reaching the part of your body where it can do the most good.
This targeted approach avoids the common pitfalls of other supplements, making sure your investment in your gut health isn't wasted. If you're serious about supporting your digestive system, strengthening your gut barrier, and cultivating a balanced microbiome, choosing a supplement with this patented technology is a game-changer.
You can experience this superior delivery system for yourself. Learn more about Peak Performance’s Tributyrin Postbiotics Capsules with CoreBiome, which are specifically designed for maximum bioavailability and targeted gut support. The science behind this unique form makes it an exceptional choice for anyone looking to go beyond basic gut health supplements.
The Health Benefits of Tributyrin Supplementation

So, we've seen how a corebiome tributyrin supplement is engineered to deliver butyrate right where it’s needed. Now, let’s get into the good stuff: what does this targeted fuel actually do for you? The benefits aren't just about "gut health" in a vague sense. We're talking about specific, tangible improvements that can change how you feel and function every single day.
When you directly nourish your colon, you kick off a chain reaction of positive effects that ripple throughout your entire body. It’s not just a quick fix; it’s about rebuilding the very systems that keep you healthy and resilient. Let's break down the key benefits you can expect.
Fortifying the Intestinal Wall for Better Immune Defense
Think of your gut lining as your body's most important fortress. It’s a massive barrier, just a single cell thick, that stands between your internal world and everything you ingest. When that wall is strong and the "tight junctions" between its cells are secure, it acts like an elite security guard, letting good things in and keeping bad things out.
But when butyrate is in short supply, that wall starts to weaken. This can lead to increased intestinal permeability, what many people call "leaky gut." This is bad news, as it allows unwanted particles—toxins, bits of undigested food, and pathogens—to sneak into your bloodstream where they absolutely don't belong, triggering a system-wide immune response.
A corebiome tributyrin supplement provides the direct energy your colon cells need to repair themselves and reinforce those critical tight junctions. This fortification delivers two huge wins:
- A Calmer Immune System: With a sealed gut barrier, your immune system isn't constantly freaking out over foreign particles "leaking" through. It can finally stand down from high alert.
- Stronger Pathogen Defense: A healthier, more robust gut lining is much better at preventing harmful bacteria and viruses from gaining a foothold and causing trouble.
Considering that roughly 70% of your immune system is located in your gut, keeping this barrier in top shape is one of the most powerful things you can do for your overall health.
Fostering a Balanced Gut Microbiome
A healthy gut isn't a sterile environment—it’s a bustling metropolis of trillions of microorganisms. The secret to gut wellness is keeping the peace by ensuring the beneficial bacteria outnumber the troublemakers. This is where butyrate steps in as a master regulator.
Imagine butyrate as the master gardener of your internal ecosystem. It actively cultivates an environment where the good guys thrive and the bad guys are crowded out. For example, butyrate helps lower the pH in the colon, making it more acidic and far less welcoming to many common pathogens.
A well-fed gut is a balanced gut. Butyrate doesn't just feed your colon cells; it kicks off a positive feedback loop. A gut rich in butyrate encourages the growth of other butyrate-producing bacteria, creating a self-sustaining cycle of wellness.
This means supplementing with tributyrin isn't just a temporary patch. You're helping to rebuild and sustain a more diverse, resilient microbial community for the long haul, leading to more consistent digestive comfort and better health down the line.
Enhancing Cognitive Function Through the Gut-Brain Axis
The gut-brain axis—that constant, two-way highway of communication between your gut and your brain—is one of the most fascinating frontiers in health science. What happens in your gut doesn't stay in your gut; it directly influences your mood, focus, and mental clarity.
Inflammation is a major villain in this story. When your gut is inflamed, it bombards your brain with stress signals, contributing to that all-too-common "brain fog," low moods, and an inability to concentrate. Butyrate is a powerhouse anti-inflammatory right at the source.
By tamping down inflammation in the gut, butyrate helps turn down the volume on those inflammatory signals reaching the brain. This can lead to:
- Improved Mental Clarity: Less background noise from inflammation means sharper thinking and better focus.
- Mood Support: A calm gut often translates to a more stable and positive outlook.
- Better Stress Resilience: A healthy gut-brain connection helps your body manage stress more effectively.
When you invest in your foundational gut health, you're also making a direct investment in the performance of your brain. To see these benefits for yourself, you need a supplement designed for maximum impact. If you're ready, you can check out Peak Performance's Tributyrin Postbiotics Capsules (with corebiome), which leverage this patented technology to make sure you get the results you're looking for.
How to Choose a High-Quality Tributyrin Supplement
With all the buzz around postbiotics, the supplement aisle is getting more and more crowded. It can be tough to tell a genuinely powerful corebiome tributyrin supplement from a cheap imitation. Let's be clear: not all products are made equal, and picking the right one is absolutely crucial if you want to see real results for your gut health.
So, how do you make a confident choice? It’s not about flashy marketing. It’s about looking for a few simple, verifiable quality markers that prove you’re getting a safe, pure, and effective product. By focusing on a few non-negotiable standards, you can easily filter out the noise and find a supplement that actually works.
Look for the Patented CoreBiome® Ingredient
First thing’s first: check the label for the patented CoreBiome® form of tributyrin. This isn't just a fancy brand name; it's your guarantee of a specific, clinically studied molecular structure designed for targeted delivery. As we've covered, this patented form acts like a protective shield, getting the butyrate all the way through your stomach and small intestine to the colon, right where it needs to be.
If a product just lists "butyrate" or "tributyrin" without the CoreBiome® seal, you have no guarantee it has this advanced delivery system. That could mean the butyrate gets absorbed way too early in the gut, making it far less effective.
When you choose a supplement with CoreBiome®, you're choosing predictable, reliable delivery. It's the difference between a package that gets lost in the mail and one that arrives with guaranteed next-day delivery, right to your doorstep.
This specific, patented ingredient is the gold standard for both purity and targeted release. It should be the very first thing you look for.
Insist on Third-Party Testing for Purity and Potency
Any reputable supplement company will go the extra mile to prove its product is legit through independent verification. This is called third-party testing, and it means an unbiased, outside lab has analyzed the supplement to confirm two critical things:
- Potency: Does the bottle contain the exact amount of tributyrin the label says it does? You should always get what you pay for.
- Purity: Is the product free from nasty contaminants like heavy metals, microbes, or common allergens?
This level of transparency is non-negotiable for anything you're putting into your body. It’s the ultimate peace of mind that a product is both safe and effective. Brands that openly share their test results are showing a real commitment to quality that you can trust.
Seek Clean Formulations Without Unnecessary Additives
Finally, always flip the bottle over and read the "other ingredients" list. A top-tier corebiome tributyrin supplement should have a clean, straightforward formula. You’re paying for the active ingredient, not a laundry list of artificial colors, flavors, or useless fillers and binders.
Look for formulas that are free from common allergens like gluten, soy, and dairy. The cleaner, the better. It shows the manufacturer is focused on delivering pure, functional nutrition without adding junk that could cause a reaction or get in the way of the main ingredient's job.
Keeping these strict criteria in mind, the Tributyrin Postbiotics Capsules (with corebiome) from Peak Performance really set the standard for quality. They’re built around the patented CoreBiome® ingredient, undergo rigorous third-party testing, and stick to a clean formula, making them a fantastic choice. These same principles of purity and bioavailability apply to other foundational nutrients, too. You can learn more about what to look for when choosing essential amino acids capsules to support your overall wellness.
Global Trends Driving Demand for Gut Solutions
The surge in popularity for corebiome tributyrin supplements isn't happening by chance. It's riding a massive global wave of people looking past basic gut health and demanding smarter, science-backed solutions. More and more, we're recognizing that a healthy gut is the foundation for total-body wellness.
As people get more informed, they’re no longer settling for a generic "probiotic" and hoping for the best. They're hunting for specific ingredients with proven effects and real, tangible benefits. This is exactly what's fueling the demand for advanced postbiotics like tributyrin.
This shift is incredibly clear when you look at how the research and the market are starting to sing the same tune.
From Animal Nutrition to Human Wellness
Here's something you might find interesting: some of the most powerful proof for tributyrin's benefits didn't start with humans. It actually came from the world of animal nutrition.
For years, it’s been a go-to for promoting gut integrity and healthy growth in livestock. This gave scientists a huge amount of data on its safety and effectiveness. This extensive research lit up its incredible gut-protective properties, making the jump to human supplements a completely logical and scientifically sound next step.
So, when you choose a supplement with CoreBiome®, you aren't just jumping on a new trend. You're tapping into decades of established science that has now been fine-tuned for human health.
Regional Drivers and Market Dynamics
While the demand for top-tier gut solutions like tributyrin is growing everywhere, different parts of the world have their own unique drivers. In North America, a strong focus on health and wellness, combined with friendly regulations, has made it easier for advanced ingredients to enter the market.
Over in Europe, the push comes from a huge interest in functional foods and strict rules that favor natural, effective ingredients, especially in places like Germany, France, and the UK. You can explore more on these global market trends to see the full picture.
This worldwide validation really drives home a key point: the need for effective butyrate delivery is a universal concern. Whether it's pushed by regulations or by people demanding better results, the conclusion is the same—tributyrin is at the cutting edge of modern nutrition.
This global momentum reinforces why it’s so important to pick a well-researched, high-quality solution. Just as tributyrin provides direct fuel for your colon, other gut-supportive ingredients play their own critical roles. For instance, getting enough fiber is also non-negotiable for overall gut function. You might want to check out our Organic 3-in-1 Prebiotic Fiber to see how prebiotics and postbiotics can work together.
Ultimately, by choosing a product like the Tributyrin Postbiotics Capsules (with corebiome), you're aligning your health strategy with the very latest scientific understanding and global wellness trends. You’re choosing a supplement backed by a long history of research and validated by a growing international market that demands results you can actually feel.
Your Top Questions About CoreBiome Tributyrin
Stepping into the world of new supplements always brings up questions. And when it’s something as specific as a CoreBiome tributyrin supplement, you deserve clear, straight-up answers. We've gathered the most common questions right here to help you feel confident about supporting your gut health.
Let's dive in.
How Long Until I Notice a Difference?
This is the big question, isn't it? The honest answer is that it really depends on you—your diet, the current state of your gut, and how consistently you take it. That said, many people report feeling a change in digestive comfort and regularity within the first few weeks of daily use.
For the deeper benefits, like strengthening your gut lining and supporting your immune system, you'll want to give it a bit more time. It generally takes 1 to 3 months of consistent use for butyrate levels to build up in the colon and really get to work. Patience and consistency are your best friends here.
Can I Combine Tributyrin With My Probiotic?
Absolutely. In fact, it’s one of the smartest things you can do for your gut. Taking a CoreBiome tributyrin supplement with your daily probiotic creates a powerful one-two punch for gut health.
Think of it this way:
- Probiotics are like the "workers"—they add beneficial bacteria to your gut ecosystem.
- Tributyrin is the "fuel"—it delivers the finished product (butyrate) that directly nourishes your colon cells and creates a healthy environment for those workers.
When you combine them, you’re not just introducing good microbes; you're also giving them the perfect place to set up shop and thrive. The whole system works better together.
One of the best ways to tackle gut health is from multiple angles. A high-fiber diet feeds your native bacteria (prebiotic), a quality probiotic introduces new friendly microbes, and a tributyrin supplement gives your colon the direct fuel it craves. It’s a complete, well-rounded strategy.
Is Taking Tributyrin Better Than Just Eating More Fiber?
A diet packed with diverse fibers is non-negotiable for a healthy gut, but it doesn't always guarantee you're getting enough butyrate. Why? Because your ability to turn that fiber into butyrate depends entirely on the specific microbes you have living in your gut. Some people are just naturally less efficient at this conversion process, no matter how much broccoli they eat.
A CoreBiome tributyrin supplement neatly sidesteps that whole biological lottery. It delivers butyrate directly where it needs to go, giving you a reliable and effective dose every single time. It's the perfect partner to a high-fiber diet, acting as an insurance policy for your butyrate levels.
Ready to experience the targeted benefits of a premium postbiotic? The Peak Performance Tributyrin Postbiotics Capsules (with corebiome) are formulated with patented CoreBiome® for superior delivery, third-party tested for purity, and designed to provide the foundational support your gut needs.
Also in Blog

A Guide to Third Party Tested Supplement Brands

Dietary Supplement B12: The Scientific Link to Fighting Anemia and Boosting Energy




